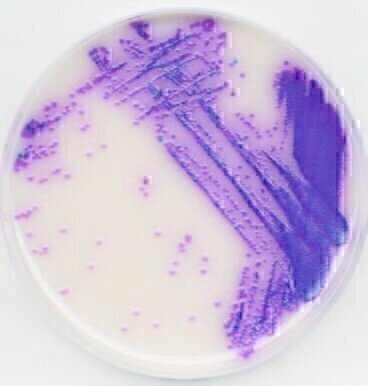
Identifying Salmonella Species in Duck Eggs in Two Days

Laboratory products
Identifying Salmonella Species in Duck Eggs in Two Days
Feb 09 2011
Thermo Fisher Scientific, Inc has announced that its Oxoid Salmonella Precis™ culture method provides fast and reliable detection of Salmonella species in food, animal feed and environmental samples. In light of the recent outbreak of Salmonella Typhimurium DT8 in Ireland, linked with the consumption of duck eggs, food testing laboratories require methods which can rapidly and accurately identify salmonella species in food. The latest cases have been linked to the consumption of duck eggs from small backyard flocks and private farms. Salmonella is a genus of rod-shaped, Gramnegative Enterobacteriaceae known to cause symptoms that vary from vomiting and diarrhea to life threatening illness.
In response, the Department of Agriculture, Fisheries and Food (DAFF) has published a code of practice for commercial flock owners. The code specifies that flocks must have an effective Salmonella monitoring programme in place and comply with the minimum levels recommended by DAFF. Duck flocks intended for the production of table eggs should be tested for Salmonella at least at the day-old stage, at four weeks of age, at two weeks before moving to the laying phase or laying unit, at 22 to 28 weeks and every 15 weeks during the laying phase. Given that a commercial flock breeds hundreds of ducks at different ages, Salmonella monitoring at such a facility is a continuous process requiring fast turnaround of results in order to detect contamination as early in the process as possible.
The Oxoid Salmonella Precis culture method achieves the fast turnaround times required for Salmonella monitoring. The procedure is carried out in just two days, in three simple steps – enrichment, plating and confirmation. The single 18-hour enrichment is achieved using Oxoid ONE Broth-Salmonella, a highly nutritious medium that promotes recovery and growth of the target organism while inhibiting competing organisms. The growth promoter in the medium allows the recovery of stressed Salmonella cells, even when present in very low numbers. Plating is undertaken on Oxoid Brilliance™ Salmonella Agar that incorporates Inhibigen™ technology, which improves the recovery of Salmonella by reducing background flora. The identification is confirmed using the Oxoid Salmonella Latex Test, a quick and easy method for the confirmation of Salmonella species from culture media.
Digital Edition
Lab Asia Dec 2025
December 2025
Chromatography Articles- Cutting-edge sample preparation tools help laboratories to stay ahead of the curveMass Spectrometry & Spectroscopy Articles- Unlocking the complexity of metabolomics: Pushi...
View all digital editions
Events
Jan 21 2026 Tokyo, Japan
Jan 28 2026 Tokyo, Japan
Jan 29 2026 New Delhi, India
Feb 07 2026 Boston, MA, USA
Asia Pharma Expo/Asia Lab Expo
Feb 12 2026 Dhaka, Bangladesh